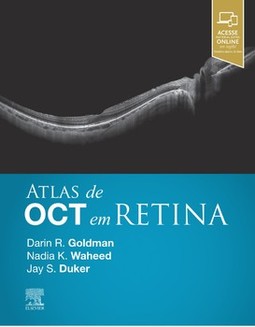

CADASTRE-SE
ATLAS DE OCT EM RETINA
Jay S. Duker , Darin R. Goldman , Nadia K. Waheed (0) votos | (0) comentários
Sinopse
Aproveite ao máximo OCT em sua prática com este atlas único e de alta qualidade. A Tomografia de Coerência Óptica revolucionou o atendimento oftalmológico. Esta tecnologia única e não-invasiva não tem paralelos no auxílio no diagnóstico de doenças retinianas e na análise do progressão. O Atlas de OCT em Retina oferece um guia avançado nesta área, em constante evolução, com imagens de extrema qualidade, que mostram detalhes precisos e permitem tomada de decisões de forma rápida e acurada no dia a dia. - Mais de 470 imagens ilustrativas que abordam o espectro completo das doenças retinianas utilizando scans de OCT, além de retinografias e outras tecnologias diagnósticas. - Grandes imagens de alta resolução, com setas e marcações, que guiam o leitor durante a leitura. - Inclui a mais moderna tecnologia de OCT de domínio espectral e novos achados da tecnologia de angiografia por OCT para assegurar que o leitor tenha à disposição casos ilustrativos atualizados e de máxima qualidade. - Oferece os principais achados para cada doença, apontando os pontos que o leitor precisa saber sobre OCT, permitindo assim rápidas compreensão e referência. - Expert Consult® - eBook em inglês incluído na compra do livro. O eBook em inglês permite a pesquisa por todo o texto, figuras e referências, por meio de múltiplos dispositivos.
| Categoria | |
| Editora | Grupo GEN |
| ISBN-13 | 9788535291988 |
| ISBN | 8535291989 |
| Edição | 1 / 2019 |
| Idioma | Português |
| Páginas | 224 |
| Estante | 0 0 0 0 |
| Sua estante | |
8% chance de ser solicitado
CADASTRE-SE
AVALIAÇÃO DO LEITOR
Quero comentar sobre este livro